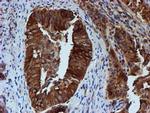
TUBB4 Antibody in Immunohistochemistry (Paraffin) (IHC (P))
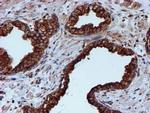
TUBB4 Antibody in Immunohistochemistry (Paraffin) (IHC (P))

Search
OriGene
TUBB4 Monoclonal Antibody (OTI8E3), TrueMAB™
{{$productOrderCtrl.translations['antibody.pdp.commerceCard.promotion.promotions']}}
{{$productOrderCtrl.translations['antibody.pdp.commerceCard.promotion.viewpromo']}}
{{$productOrderCtrl.translations['antibody.pdp.commerceCard.promotion.promocode']}}: {{promo.promoCode}} {{promo.promoTitle}} {{promo.promoDescription}}. {{$productOrderCtrl.translations['antibody.pdp.commerceCard.promotion.learnmore']}}
产品信息
TA503110
种属反应
宿主/亚型
分类
类型
克隆号
抗原
偶联物
形式
浓度
纯化类型
保存液
内含物
保存条件
运输条件
靶标信息
TUBB4A (beta-4 tubulin) encodes a member of the beta tubulin family. Beta tubulins are one of two core protein families (alpha and beta tubulins) that heterodimerize and assemble to form microtubules. Mutations in this gene cause hypomyelinating leukodystrophy-6 and autosomal dominant torsion dystonia-4. Alternate splicing results in multiple transcript variants encoding different isoforms. A pseudogene of this gene is found on chromosome X.
仅用于科研。不用于诊断过程。未经明确授权不得转售。
篇参考文献 (0)
生物信息学
蛋白别名: dystonia 4, torsion (autosomal dominant); Tubulin 5 beta; tubulin beta; Tubulin beta-4 chain; Tubulin beta-4A chain; tubulin, beta 4; tubulin, beta 4A class IVa; tubulin, beta, 5
基因别名: beta-5; DYT4; TUBB4; TUBB4A; TUBB5
UniProt ID: (Human) P04350
Entrez Gene ID: (Human) 10382